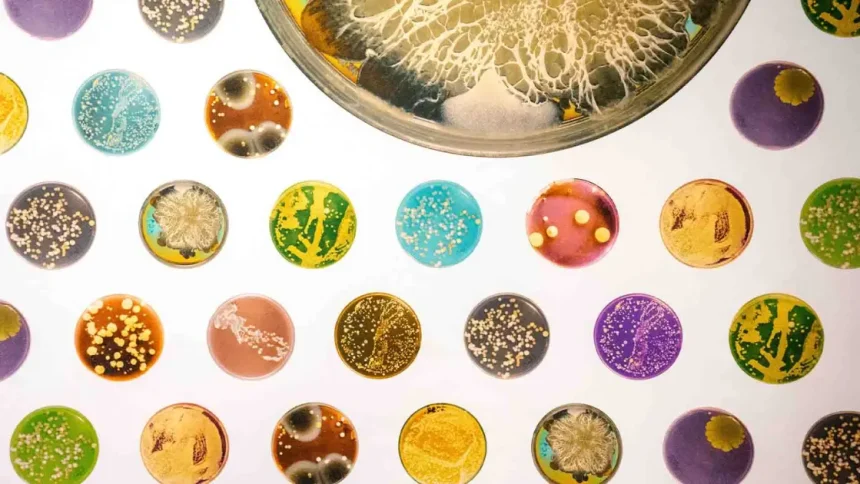
«Ανακαλύψτε γιατί ορισμένα μικρόβια είναι οι καλύτεροι σύμμαχοι για την υγεία σας!»

Ο ανθρώπινος οργανισμός φιλοξενεί τρισεκατομμύρια μικροοργανισμούς, κυρίως στο έντερο, στο δέρμα και στο αναπνευστικό σύστημα. Αυτοί οι μικροβιακοί πληθυσμοί παίζουν κρίσιμο ρόλο στην ρύθμιση του ανοσοποιητικού συστήματος, διευκολύνουν τη διαδικασία της πέψης και εκπαιδεύουν τον οργανισμό να διακρίνει τις πραγματικές απειλές από αβλαβή ερεθίσματα.
Μια πρόσφατη μελέτη από το Flinders University έρχεται να ενισχύσει αυτήν την αντίληψη, μετατοπίζοντας τη δημόσια συζήτηση γύρω από τους μικροοργανισμούς από το φόβο προς την αναγνώριση της λειτουργικής τους αξίας για την υγεία μας. Οι ερευνητές δημιούργησαν μια καινοτόμο βάση δεδομένων που καταγράφει ευεργετικούς μικροοργανισμούς και φυσικές βιοχημικές ενώσεις, οι οποίες συνδέονται με την ενίσχυση του ανοσοποιητικού, τη μείωση του άγχους και την αύξηση της ανθεκτικότητας του οργανισμού. Τα ευρήματα δείχνουν ότι η αλληλεπίδραση με πλούσια σε μικροβιακά περιβάλλοντα, κυρίως σε φυσικά οικοσυστήματα, δεν είναι μια απειλή, αλλά μια προϋπόθεση για την υγιή ισορροπία του ανθρώπινου σώματος.
Συγκεκριμένα, οι επιστήμονες εντόπισαν 124 μικροβιακές ομάδες και 14 φυσικές βιοχημικές ενώσεις που ενδέχεται να έχουν θετικές επιπτώσεις, όπως η ρύθμιση του ανοσοποιητικού συστήματος, η μείωση του άγχους και η καταπολέμηση της φλεγμονής.
Για όσους ενδιαφέρονται να εμβαθύνουν στο αντικείμενο, μπορούν να ανατρέξουν στην αναλυτική παρουσίαση της έρευνας, η οποία παρέχει εκτενή στοιχεία και υποστηρίξεις για τα ευρήματα αυτά.